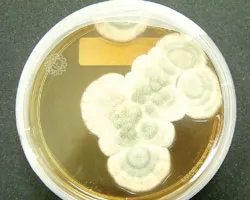
Thành công  nhờ... sự tình cờ

Cuối năm, 508 hộ kinh doanh ở chợ vải Soái Kình Lâm (còn có tên là Thương xá Đồng Khánh) hối hả hơn với các cú điện thoại đặt hàng từ mọi miền đất nước, kể cả tận Campuchia. Hàng chục năm nay, cách mua bán sỉ ở chợ vải này vẫn như thế: bạn hàng gọi điện thoại (trước đây thì viết thư, gửi điện tín) để đặt hàng, chủ sạp theo đó mà gửi hàng, sau khi nhận được hàng, khách mới gửi tiền trả.
Trước ngày giải phóng miền Nam năm 1975, chợ vải chỉ là một phiên “chợ chạy”, tức là hễ cảnh sát ngụy truy rượt thì tiểu thương “chạy”! “Sau ngày đất nước thống nhất, tiểu thương tụi tui tập trung bán trên đường Lò Vôi (P14, Q5) cho tới năm 1980 thì Nhà nước cho vào chợ bán như hiện nay”, bà Nguyễn Thị Hai, một tiểu thương lâu năm cho biết. Theo lời bà Hai kể, thời “ngăn sông cấm chợ”, chợ vải chỉ bán vải nhập lậu từ Trung Quốc và các nước Đông Âu. Thời gian sau, bà con lại chuyên bán vải dệt trong nước do các cơ sở bên quận 11 sản xuất, nhuộm bằng thứ dầu hôi đặc trưng...

Một góc chợ vải Soái Kình Lâm.
Ảnh: M.A.
Khoảng mười năm nay, kinh tế đất nước khởi sắc, chợ vải bán từ 6 giờ sáng đến 6 giờ chiều tại 3 trung tâm nằm trên đường Trần Hưng Đạo và Đỗ Ngọc Thạnh (trong đó 2 trung tâm do Ban quản lý chợ quản lý, 1 trung tâm do Sở Thương mại quản lý). Phó BQL chợ, bà Trương Thúy Phượng, cho biết: “Tiểu thương ở đây bán theo kiểu “mẹ truyền, con nối” và có đến 30% là phụ nữ người Hoa.
Đặc trưng của chợ là phía dưới đất thì bày hàng sát mặt đường phố để bán, còn ở trên là các căn phố lầu thuộc chung cư Soái Kình Lâm cũ kỹ”. Vào thăm sạp số 1, chúng tôi gặp tiểu thương Ngô Thị Mỹ, nhà ở quận 6. Chị Mỹ niềm nở: “Mẹ tôi là bà Ngô Mùi bán mấy chục năm nay rồi. Nay mẹ tôi già yếu, tôi ra bán thay mẹ. Bán trong chợ thì diện tích hơi hẹp, chỉ 4m2, nhưng phải đóng thuế mỗi tháng khoảng 7 triệu đồng đó”.
Gắn bó với ngôi chợ-phố Soái Kình Lâm từ thuở ban sơ, anh Bùi Mạnh Chung - Phó trưởng BQL- hân hoan thông báo: “Bây giờ thì ăn theo chợ, khoảng 200 tiểu thương khác đã mở sạp, cửa hàng trên các tuyến đường Dương Tử Giang, Đỗ Ngọc Thạnh, Nguyễn Trãi... rồi, số này do UBND phường 14, quận 5 quản lý, bà con buôn bán sung túc lắm. Trung bình một sạp bán hàng thun dệt kim đưa ra thị trường 1.000kg thun/ngày (7.000-12.000đ/kg), đủ thấy sức chi phối ở chợ đối với thị trường vải cả nước. Năm 2006 này, bà con nộp ngân sách 5,4 tỷ đồng”.
Chợ-phố Soái Kình Lâm sắp “lên đời”, đó là chuyện thời sự của bà con trong những ngày cuối năm. Tiểu thương Ngô Thị Vân (sạp A.9) cho biết, sau khi chung cư Soái Kình Lâm giải tỏa, một trung tâm thương mại mới cao 27 tầng sẽ được xây dựng, tiện nghi hơn, sang trọng hơn và chắc chắn là sẽ buôn bán đắt hơn. Trong thời điểm này nói lời tạm biệt với ngôi chợ vải lâu năm này e là quá sớm nhưng người đi chợ hiện có thể thấy rất rõ những người thợ xây đang tiến hành tháo dỡ chung cư Soái Kình Lâm.
MINH ANH